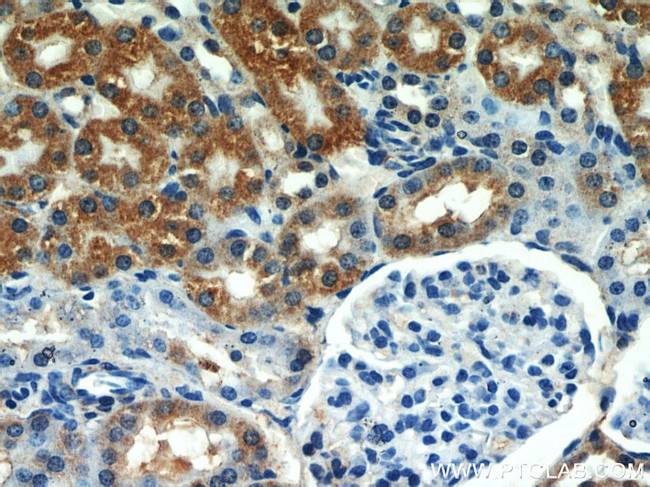
SEPX1 Antibody in Immunohistochemistry (Paraffin) (IHC (P))

Search
Proteintech
SEPX1 Polyclonal Antibody
{{$productOrderCtrl.translations['antibody.pdp.commerceCard.promotion.promotions']}}
{{$productOrderCtrl.translations['antibody.pdp.commerceCard.promotion.viewpromo']}}
{{$productOrderCtrl.translations['antibody.pdp.commerceCard.promotion.promocode']}}: {{promo.promoCode}} {{promo.promoTitle}} {{promo.promoDescription}}. {{$productOrderCtrl.translations['antibody.pdp.commerceCard.promotion.learnmore']}}
产品信息
15333-1-AP
种属反应
宿主/亚型
分类
类型
抗原
偶联物
形式
浓度
规格
纯化类型
保存液
内含物
保存条件
运输条件
产品详细信息
Immunogen sequence: MSFCSFFGG EVFQNHFEPG VYVCAKCGYE LFSSRSKYAH SSPWPAFTET IHADSVAKRP EHNRSEALKV SCGKCGNGLG HEFLNDGPKP GQSRFUIFSS SLKFVPKGKE TSASQG (1-115 aa encoded by B C003127)
靶标信息
This gene encodes a selenoprotein, which contains a selenocysteine (Sec) residue at its active site. The selenocysteine is encoded by the UGA codon that normally signals translation termination. The 3' UTR of selenoprotein genes have a common stem-loop structure, the sec insertion sequence (SECIS), that is necessary for the recognition of UGA as a Sec codon rather than as a stop signal. This protein belongs to the methionine sulfoxide reductase B (MsrB) family, and it is expressed in a variety of adult and fetal tissues.
仅用于科研。不用于诊断过程。未经明确授权不得转售。
生物信息学
蛋白别名: methionine sulfoxide red. domain; methionine sulfoxide reductase b; Methionine-R-sulfoxide reductase B1; MGC3344; MsrB1; Selenoprotein R; Selenoprotein X; selenoprotein X 1; selenoprotein X, 1; SelR; SelX
基因别名: D17Wsu82e; HSPC270; MSRB1; SELENOR; SELENOX; SELR; SELX; SepR; SEPX1
UniProt ID: (Human) Q9NZV6, (Rat) Q52KJ8, (Mouse) Q9JLC3
Entrez Gene ID: (Human) 51734, (Rat) 685059, (Mouse) 27361